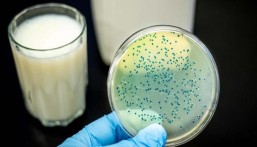
قد تنقل المرض للإنسان.. 5 حيوانات عرضة للإصابة بـ “الحمى المالطية”

حذّرت دراسة أجراها باحثون في جامعة هانجتشو الصينية، من أن تناول كميات كبيرة من البطاطس المقلية بشكل متكرر قد يزيد من فرصة الإصابة بحالات القلق والاكتئاب.
وأوضحت الدراسة التي استغرقت 11 عاماً، وفقاً لموقع “wionews” الصيني، أن الاستهلاك المُتكرر للأطعمة المقلية ومنها البطاطس يرتبط بارتفاع خطر الإصابة بالقلق والاكتئاب بنسبة 12%.
وجاءت هذه النتائج بعد رصد الأعراض الصحية لمجموعة مؤلفة من 140 ألف شخص، عقب تناول كل منهم لوجبات تحتوي على مواد غذائية متنوعة بشكل يومي ومتكرر.